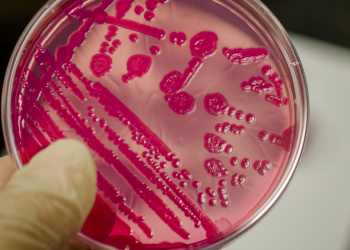
63174193ae281

06/09/2022 - Laboratórios Sanuvitas oferece ensaio de Tipificação de Salmonella pela técnica Microarranjo de DNA
Fundado em 2017, o Sanuvitas Laboratórios Ltda está localizado em Garibaldi, na Serra Gaúcha, e em seu nome traz o significado de sua essência: promover saúde e vida. Aplicando seu significado em uma conjuntura de saúde única – One Health – oferece serviços em análises laboratoriais que atendem toda a cadeia produtiva de alimentos, do campo à mesa.
Com propósito de inovar e oferecer ao setor avícola serviços que validem e garantam o compromisso em sanidade, biosseguridade e segurança alimentar, em 2019 o Laboratórios Sanuvitas iniciou a implementação do ensaio de Tipificação de Salmonella, pela técnica microarranjo de DNA. Em 2021 conquistaram a acreditação junto a CGCRE/INMETRO e agora conquistaram credenciamento junto ao MAPA.
Identificação molecular de Salmonelas: Inovação em ensaios

Com este credenciamento, o Laboratórios Sanuvitas passa a atender os requisitos descritos no Ofício nº42/2019/CDL/CGAL/DAS/MAPA de 09/05/2019 e está autorizado a realizar a identificação molecular de Salmonelas nas áreas de diagnóstico animal e microbiologia de alimentos, em atendimento aos Programas e Controles Oficiais do MAPA.
• Ensaio: Caracterização molecular de sorovares de Salmonella pelo método Microrray - Check & Trace Salmonella®
• Técnica: Microarranjo de DNA
• Matriz/espécie: Cepas purificadas de Salmonella spp.
O ensaio Tipificação de Salmonella por técnica Microarranjo de DNA oportuniza identificar em 8 horas, 354 sorovares distintos de Salmonella. Trata-se de uma conquista inédita ao se tornar o primeiro e único laboratório do Brasil credenciado junto ao MAPA para o referido ensaio/técnica/matriz. Para maiores informações consulte o escopo credenciado Laboratórios Sanuvitas através do site www.sanuvitas.com.br
Créditos da Imagem: Laboratório Sanuvitas

Contato
Área Restrita